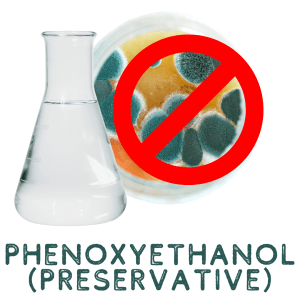

🐄 Burned • Chapped • Dry Skin Types 🏵️
2 Skincare Functions
💧 Moisturizer to nourish, soften, protect, and smooth your skin
🩹 Recovery to help strengthen your skin’s barrier and support the end-healing process
9 Ingredients
Grass-Fed Local Suet Tallow
Animal Fat is the original beauty ingredient used by our ancestors since ancient times
Dry-Rendered in-house by the hands of our skilled staff to retain maximum nutrients and benefits
Bioavailable moisturization with skin-compatible natural nutrients to feed and strengthen your epidermis
Uniquely Rich in Vitamin D3, Stearic Acid, and CLA fatty acids (Conjugated Linoleic Acids) which are known to have many skincare benefits (source)
Non-Comedogenic and quickly absorbs into the skin when spread well with minimum application
Skin Benefits include a more balanced tone, calmed inflammation, softer texture, better protection, more moisturization, and anti-aging effects
Organic Aloe Vera Gel
Moisturize, Hydrate, & Protect your skin with this creamy-textured ingredient
Thousands of Years in skincare use for soothing dryness, acne, inflammation, burns, rashes, and more
Amino Acids, Vitamins, & Minerals contribute to a healthier epidermis
Anti-Inflammatory properties reduce the appearance of blemishes and wrinkles
American Emu Oil
Pasture-Raised emu oil contains the highest naturally occurring food source for Vitamin K2 MK-4 in addition to fat-soluble vitamins A, D3, & E.
Anti-Aging emu oil helps collagen production, prevent wrinkles, improve skin elasticity, diminish stretch marks and scarring from burns and cuts.
Anti-Inflammatory compounds help to soothe and reduce skin irritation. It may be beneficial for conditions such as eczema, psoriasis, and acne.
Anti-Microbial to fight bacteria that contribute to chronic epidermal infections such as acne and dermatitis.
Unique Fatty Acids: Contains an abundance of beneficial and balanced fatty acids like Omega-3,6,7 & 9 plus CLA.
Moisturizing: Emu oil is rich in fatty acids, including oleic acid and palmitic acid, which help to hydrate and soften the skin. It can penetrate deep into the skin layers, providing long-lasting moisture.
Wound Healing: Emu oil has been shown to promote wound healing by stimulating collagen production and improving blood circulation.
Scar Reduction: Emu oil may help to minimize the appearance of scars.
Antioxidant Protection: Emu oil contains antioxidants, such as vitamin E, which can help to protect the skin from free radical damage.
Organic Apple Cider Vinegar
Antibacterial Properties: Diluted acetic acid in ACV has been shown to kill bacteria and help prevent infection in burn wounds.
Sunburns: Diluted apple cider vinegar is a popular home remedy for sunburn that some people believe can help soothe pain, itching, and inflammation.
Consult a Doctor: Never use directly on an open burn wound without medical advice.
Stop When: If you experience any irritation, stop using it immediately.
Organic Calendula Flower Infusion
Certified Organic and USA-Grown for the freshest and highest quality.
4-Week Deep Infusion: Using the traditional herbalist method, we carefully and deeply infused the freshly dried flowers directly into the tallow for over 4 weeks.
Anti-Inflammatory: Calendula’s unique compounds help calm redness, swelling, and itchiness associated with skin irritation.
Heals wounds: Calendula promotes cell regeneration and helps heal minor cuts, burns, scrapes, and abrasions.
Soothing Relief: It can provide relief for conditions like eczema and diaper rash due to its soothing properties.
Fights Acne: Its antimicrobial and astringent properties can help manage acne by fighting bacteria and reducing excess oil.
Antioxidant Protection: Rich in antioxidants like flavonoids and carotenoids, it helps neutralize free radicals that can lead to skin damage from sun exposure and photo-aging.
Boosts collagen: It stimulates collagen production, which helps improve skin elasticity and reduce the appearance of fine lines and wrinkles.
Improves Skin: By eliminating dead skin cells, it can help restore a softer and smoother texture to the skin. It also assists in repairing and maintaining the skin’s natural barrier function.
Raw Local Honey
Locally Harvested for the highest and freshest quality.
Raw and minimally processed for maximum nutrient retention and benefits.
Moisturizing Properties: Raw honey is a humectant, meaning it attracts and retains moisture to help keep the skin hydrated and supple, reducing dryness and flakiness.
Antibacterial and Anti-Inflammatory Effects: Raw honey contains antibacterial and anti-inflammatory properties that can help to combat acne-causing bacteria and soothe irritated skin. This makes it beneficial for treating acne, eczema, and other skin conditions.
Antioxidant Protection: Raw honey is rich in antioxidants, which help to protect the skin from free radical damage caused by environmental factors like UV rays and pollution. This can help to reduce signs of aging, such as wrinkles and fine lines.
Enzyme Action: The enzymes in raw honey gently micro-exfoliate the skin, removing dead skin cells and revealing a brighter, smoother complexion.
Wound Healing: Raw honey has been traditionally used to promote wound healing. Its antibacterial and anti-inflammatory properties can help to prevent infections and speed up the healing process.
Other Benefits: Raw honey can help to improve skin tone and texture. It may reduce the appearance of scars and hyperpigmentation. It is a natural alternative to harsh chemical-based skin care products.
Local Beeswax
Locally Harvested for the highest and freshest quality.
Raw and minimally processed for maximum nutrient retention and benefits.
Moisturizing Properties: Beeswax acts as a natural humectant, attracting and retaining moisture in the skin.
Protective Barrier: Beeswax forms a protective layer on the skin, shielding it from environmental irritants such as pollutants, UV rays, and bacteria.
Antibacterial and Anti-inflammatory Effects: Beeswax contains antibacterial and anti-inflammatory compounds that can help to soothe and calm irritated skin.
Softening and Smoothing: Beeswax is an emollient that helps to soften and smooth the skin, improving skin texture.
Vitamin A Content: Beeswax contains small amounts of vitamin A, which is an antioxidant that promotes skin cell regeneration and improves skin elasticity.
Organic Non-GMO Vitamin E
Derived From: Non-GMO Organic Sunflowers ONLY
Allergen-Free: NO soy, wheat, gluten, or synthetic ingredients
Purest Form: There is no other purer natural Vitamin E on the market
All-Natural: D-Alpha Tocopherol has 200% more bioavailability than synthetic E
Antioxidants: Protects against environmental damages
Preservation: Lengthens shelf-life and preserves natural nutrients longer
Anti-Aging: Prevents the breakdown of collagen in skin, extending youthfulness
Skin Health: Speeds skin healing after stretching, dryness, or breakage
Moisturizing: Increases epidermal moisture-retention and consistency
Phenoxyethanol
Absolutely Necessary for a safe, water-based product that can be stored and shipped at regular room temperatures, it’s irreplaceable.
Preservative Properties: Phenoxyethanol prevents the growth of bacteria, mold, and yeast in hair products, extending their shelf life from days to years without the need to refrigerate and ensuring product stability.
Safety: When used within recommended concentrations (which we do in our formulations), phenoxyethanol is considered safe for most people. It is regulated by agencies such as the FDA and the EU.
Reduced Risk of Contamination: By inhibiting microbial growth, phenoxyethanol reduces the risk of contamination, which can lead to skin infections and other problems.
Nature-Identical to a compound found in green tea, this synthetic version is exactly the same natural chemical, but lab-made ensures the consistency and efficacy of the product.
Improved Product Consistency: Phenoxyethanol helps maintain the texture and consistency of products over time, preventing them from separating or becoming watery.

























Karin Pinheiro –
I am not a fan of covering myself in sunscreen. I like the tan! So i always need some aloe once i get my first tan/burn of the year. This april i was in puerto rico. Minimal sunscreen was used on day one and i got a burn! The aloe tallow really kept the peeling away. It was soothing and kept my skin moisturized without greasy or slimy from the regular aloe we see in stores. Thankfully the burn wasnt painful. This stuff really kept my skin hydrated throughout the process.
tkmarlow –
I have several issues with my skin postpartum, including rosacea, dryness and sensitivity. I have already used 2 containers of this and planning to continue to repurchase. This is creamy, soft, and hydrating for my super sensitive skin. Causes zero reactions. Literally the only thing I use on my face. Love!